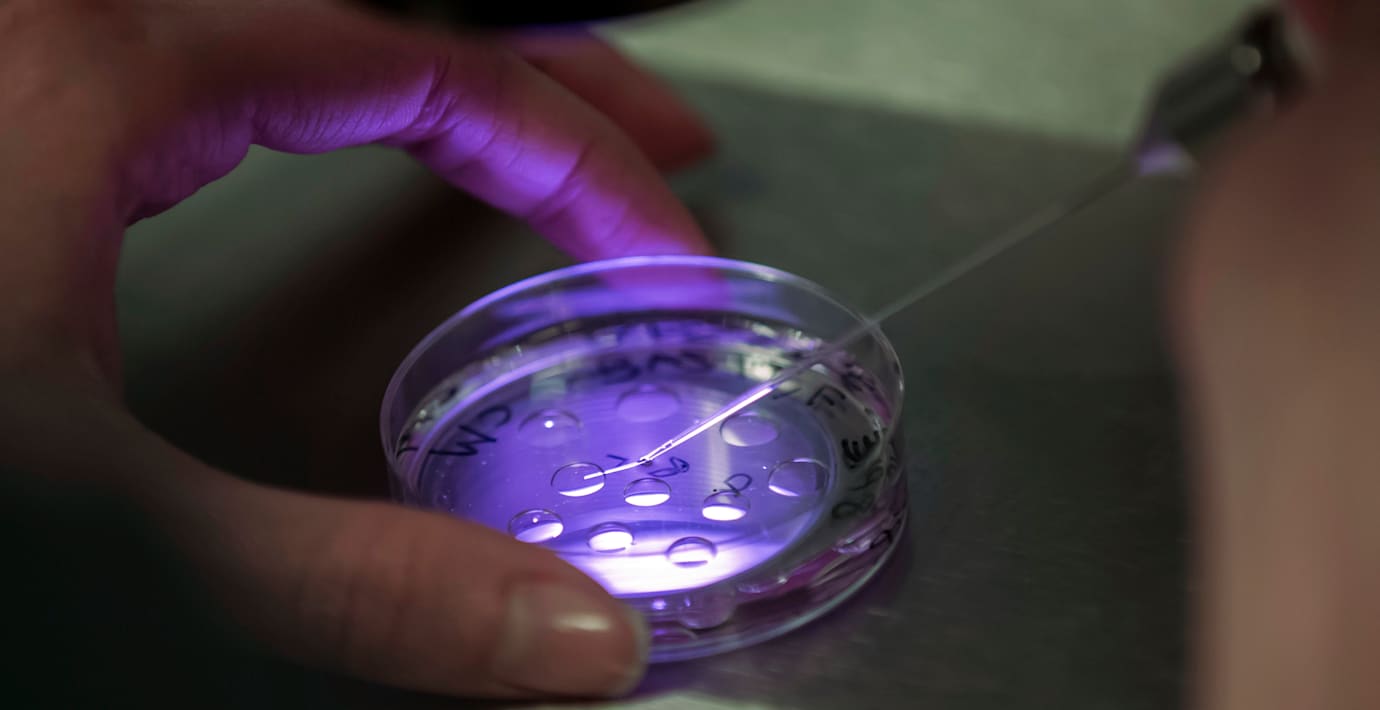

Spermosens: ”Lottning avgör vem som får minimipost”
Långt ifrån alla kommer att tilldelas en minimipost på 711 units efter den nyligen avslutade spridningsemissionen, uppger fertilitetsbolagets Spermosens i ett pressmeddelande.
Styrelsen uppger att man fått in många anmälningar, nära 9 000 stycken, och att tilldelningen därför avgjorts med lottning i flera fall.
Spermosens, som diagnoticerar manlig fertilitet, kommer att börja handlas på Spotlight 5 maj.
Omni är politiskt obundna och oberoende. Vi strävar efter att ge fler perspektiv på nyheterna. Har du frågor eller synpunkter kring vår rapportering? Kontakta redaktionen